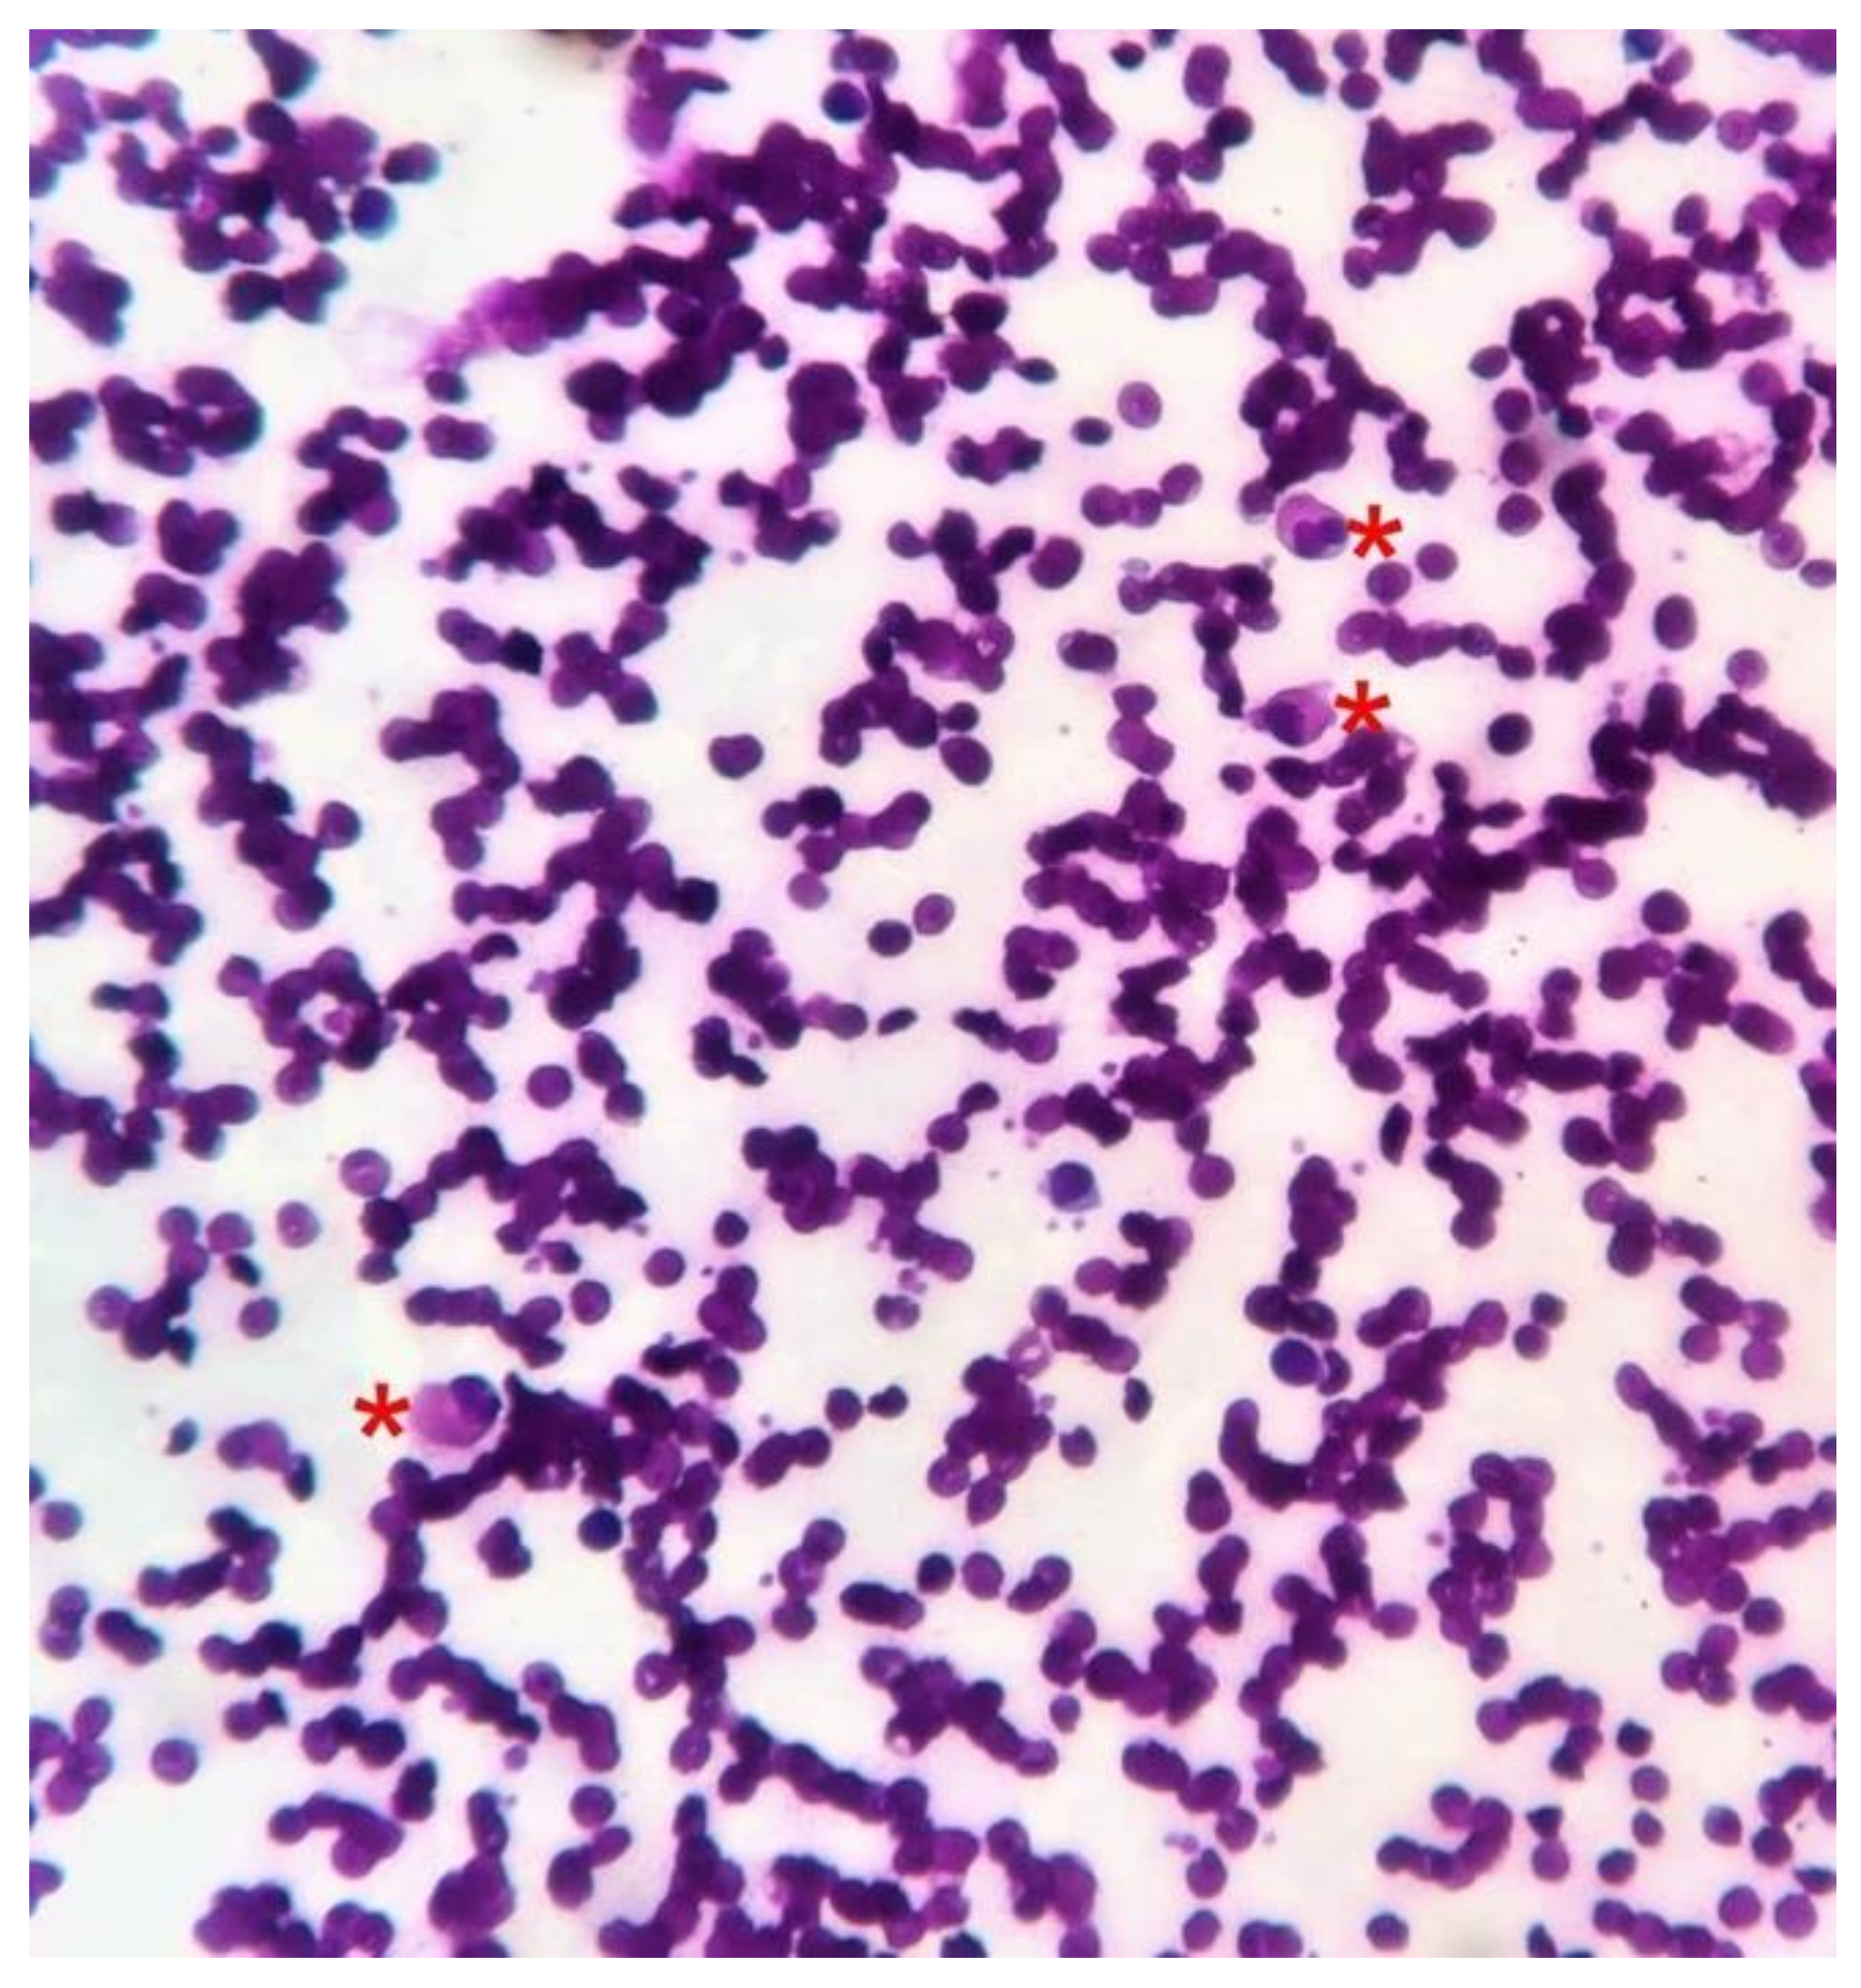
Dermatopathology 08 00002 g005

Scrotal Lymphangiectasia with Penile Elephantiasis in Underlying Lymphatic Filariasis—Challenging the Diagnostic Mind! A Case Report
Abstract
:1. Introduction
2. Case Report
3. Discussion
4. Conclusions
Author Contributions
Funding
Institutional Review Board Statement
Informed Consent Statement
Data Availability Statement
Acknowledgments
Conflicts of Interest
References
- Binitha, M.P.; Khader, A.; Sherjeena, P.B.; Rini, M.R. Acquired Cutaneous Lymphangiectasia of the Scrotum Secondary to Filarial Lymphoedema. Kerala Med. J. 2015, 8, 29–31. [Google Scholar]
- Chintagunta, S.R.; Arakkal, G. Lymphangiectasia of varied etiology: Case series. J. NTR Univ. Health Sci. 2019, 8, 125–128. [Google Scholar] [CrossRef]
- Richens, J. Genital manifestations of tropical diseases. Sex Transm. Infect. 2004, 80, 12–17. [Google Scholar] [CrossRef]
- Hagiwara, K.; Toyama, K.; Miyazato, H.; Nonaka, S. A case of acquired lymphangioma due to a suspected old filariasis and a review of literature. J. Dermatol. 1994, 21, 358–362. [Google Scholar] [CrossRef]
- Russell, B.; Pridie, R.B. Lymphoedema of scrotum-scrotectomy-lymphangiectasia of anogenital region? Congenital lymphatic deficiency and past filariasis. Br. J. Dermatol. 1967, 79, 298–299. [Google Scholar]
- Tasdelen, I.; Gokgoz, S.; Paksoy, E.; Yerci, O.; Kahraman-Cetintas, S.; Demiray, M.; Samsa, V. Acquired lymphangiectasis after breast conservation treatment for breast cancer: Report of a case. Dermatol. Online J. 2004, 10, 9. [Google Scholar] [PubMed]
- Pal, D.K.; Banerjee, M.; Moulik, D.; Biswas, B.K.; Choudhury, M.K. Lymphangioma circumscriptum of the scrotum following vasectomy. Indian J. Urol. 2010, 26, 294–295. [Google Scholar] [CrossRef] [PubMed]
- Jappe, U.; Zimmermann, T.; Kahle, B.; Petzoldt, D. Lymphangioma circumscriptum of the vulva following surgical and radiological therapy of cervical cancer. Sex Transm. Dis. 2002, 29, 533–535. [Google Scholar] [CrossRef] [PubMed]
- Bandyopadhyay, D. Scrotal lymphangiectasia following scrofuloderma. Indian J. Derm. Venereol. Leprol. 2017, 83, 397–398. [Google Scholar] [CrossRef] [PubMed]
- Errichetti, E.; Pegolo, E.; De Francesco, V. Acquired lymphangiectasia of the vulva. J. Dtsch. Dermatol. Ges. 2015, 13, 237–239. [Google Scholar] [CrossRef] [PubMed]
- WHO. Lymphatic Filariasis. Available online: https://www.who.int/en/news-room/fact-sheets/detail/lymphatic-filariasis (accessed on 3 December 2020).
- Verzì, A.E.; Lacarrubba, F.; Tedeschi, A.; Micali, G. Localized acquired lymphangiectasias after breast surgery: Enhanced non-invasive diagnosis using dermoscopy and reflectance confocal microscopy. Skin Res. Technol. 2020, 26, 205–208. [Google Scholar] [CrossRef] [PubMed]
- Jha, A.K.; Lallas, A.; Sonthalia, S. Dermoscopy of cutaneous lymphangioma circumscriptum. Dermatol. Pract. Concept. 2017, 7, 37–38. [Google Scholar] [CrossRef] [PubMed]
- Short, S.; Peacock, C. A newly described possible complication of lymphangioma circumscriptum. Clin. Oncol. (R Coll. Radiol.) 1995, 7, 136–137. [Google Scholar] [CrossRef]
- King, D.T.; Duffy, D.M.; Hirose, F.M.; Gurevitch, A.W. Lymphangiosarcoma arising from lymphangioma circumscriptum. Arch Dermatol. 1979, 115, 969–972. [Google Scholar] [CrossRef] [PubMed]

Publisher’s Note: MDPI stays neutral with regard to jurisdictional claims in published maps and institutional affiliations. |
© 2021 by the authors. Licensee MDPI, Basel, Switzerland. This article is an open access article distributed under the terms and conditions of the Creative Commons Attribution (CC BY) license (http://creativecommons.org/licenses/by/4.0/).
Share and Cite
Vishwanath, T.; Nagpal, A.; Ghate, S.; Sharma, A. Scrotal Lymphangiectasia with Penile Elephantiasis in Underlying Lymphatic Filariasis—Challenging the Diagnostic Mind! A Case Report. Dermatopathology 2021, 8, 10-16. https://doi.org/10.3390/dermatopathology8010002
Vishwanath T, Nagpal A, Ghate S, Sharma A. Scrotal Lymphangiectasia with Penile Elephantiasis in Underlying Lymphatic Filariasis—Challenging the Diagnostic Mind! A Case Report. Dermatopathology. 2021; 8(1):10-16. https://doi.org/10.3390/dermatopathology8010002
Chicago/Turabian StyleVishwanath, Tejas, Angela Nagpal, Sunil Ghate, and Aseem Sharma. 2021. "Scrotal Lymphangiectasia with Penile Elephantiasis in Underlying Lymphatic Filariasis—Challenging the Diagnostic Mind! A Case Report" Dermatopathology 8, no. 1: 10-16. https://doi.org/10.3390/dermatopathology8010002
APA StyleVishwanath, T., Nagpal, A., Ghate, S., & Sharma, A. (2021). Scrotal Lymphangiectasia with Penile Elephantiasis in Underlying Lymphatic Filariasis—Challenging the Diagnostic Mind! A Case Report. Dermatopathology, 8(1), 10-16. https://doi.org/10.3390/dermatopathology8010002





